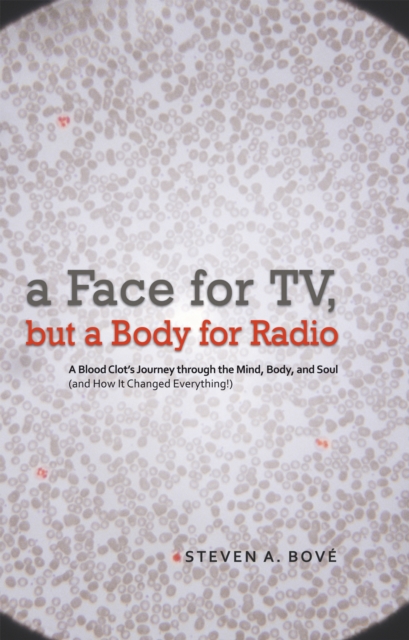
Face for Tv, but a Body for Radio

Face for Tv, but a Body for Radio
In 2004, Steven Bov almost lost his life. He had been married barely five months, and his baffling medical emergency made his new wife fear that she was about to become his widow. When excruciating pain, first felt during a workout, pushed him from doctor to doctor without answers, the newlyweds feared the worst. Soon he found himself in intensive care with his life hanging in the balance. The rea...
In 2004, Steven Bov almost lost his life. He had been married barely five months, and his baffling medical emergency made his new wife fear that she was about to become his widow. When excruciating pain, first felt during a workout, pushed him from doctor to doctor without answers, the newlyweds feared the worst. Soon he found himself in intensive care with his life hanging in the balance. The rea...
